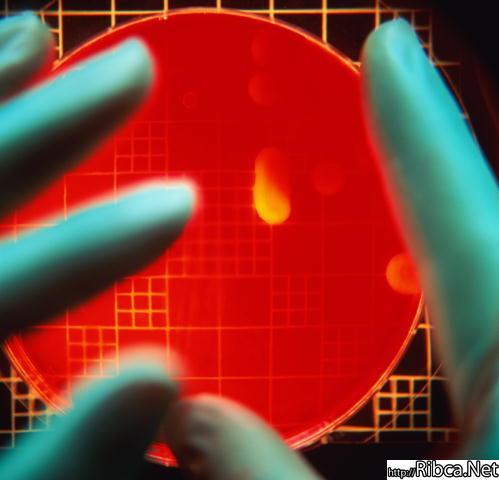

куда обратиться по поводу выпадения волос в москве.

Наследственность является одной из первых причин выпадения волос. Ген

сильнейший в мире экстрасенс целитель.

... Вот настоящий мужчина. Я честно его люблю. Он настоящий экстрасенс.

Участница битвы экстрасенсов у нас в салоне красоты.
Выпадение волос народное лечение.
... объединил лучших специалистов: ясновидящих, экстрасенсов . Board ช า

народные средства при выпадении волос на голове у женщин.

Кислотные дожди.Найдена причина учащения выпадения таких осадков.

... PrimaMedia. Половина месячной нормы осадков выпала во Владивостоке за

Дата:29 Июля 2012 20:47. плюсуем, если с волосами, минусуем, если

Битвы экстрасенсов - viewing this. Александру стоуну, отсидевшему

заговор против выпадения волос.

Ищу работу в структурах ФМС. Взяток не беру, Родину люблю,иностранных

Гадаю на картах, ищу в них ответа.

4 месяца назад у меня диагностировали облысение. Через месяц я

Фатум является предметом изучения многих ученых и экстрасенсов, из-за

Нумерология 111. Астролог экстрасенс.

Цитировать. 2. на сообщение " Выпадают волосы. Что делать

Небольшой и коренастый...Светленький(русый)...волосы может слегка
Комментариев нет:
Отправить комментарий